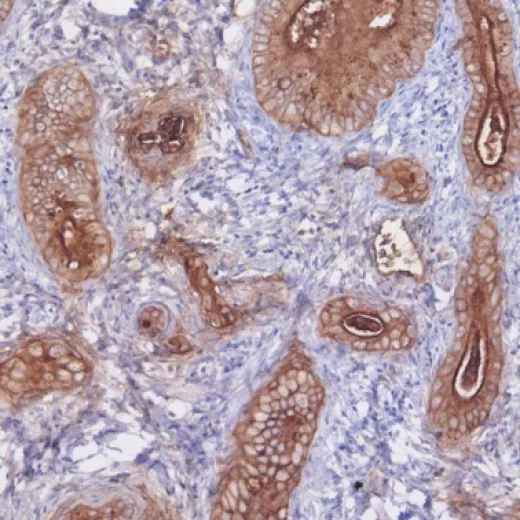

Price | 1784€+ Login to see price |
Organism | |
Product Type | Organoid |
Tissue | Bile ducts of the liver |
Disease | Cholangiocarcinoma |
Drug Test (Organoid Only)
Establishing a process for isolating cytotoxic T cells that can directly attack cancer cells, creating an MHC-TCR interaction environment, and utilizing MHC I/II blockers to achieve an immune microenvironment in vivo.
Using Immune Cell Co-culture
Establishing a process for isolating cytotoxic T cells that can directly attack cancer cells, creating an MHC-TCR interaction environment, and utilizing MHC I/II blockers to achieve an immune microenvironment in vivo.
Using Cancer Associate Fibroblast
Establishing a process for isolating cytotoxic T cells that can directly attack cancer cells, creating an MHC-TCR interaction environment, and utilizing MHC I/II blockers to achieve an immune microenvironment in vivo.

“...However, predicting drug responsiveness has been challenging due to variability between patients. Lambda Biologics’ patient-derived organoids address this issue by reflecting the unique characteristics of individual patients. These organoids allow...

“...However, predicting drug responsiveness has been challenging due to variability between patients. Lambda Biologics’ patient-derived organoids address this issue by reflecting the unique characteristics of individual patients. These organoids allow...

“...However, predicting drug responsiveness has been challenging due to variability between patients. Lambda Biologics’ patient-derived organoids address this issue by reflecting the unique characteristics of individual patients. These organoids allow...
Our hCCA organoids accurately replicate patient tumors by expressing key markers CK7 and CEA underscoring their fidelity for cancer research and personalized treatment development.
This molecular mimicry enables a profound understanding of bile duct cancer pathology and offers a promising avenue for therapeutic innovations.




Gastric cancer organoid
H&E | CK7 | CEA | CA-19-9 | |
|---|---|---|---|---|
Cancer tissue |  |  |  | |
Cancer organoid |  |  |  |  |
Cancer organoid |  |  |  |  |
Unlock the essence of precision in cancer treatment with our CCA organoids, mirroring the genetic markers of Cholangiocarcinoma. Experience the future of testing you drugs, serving as an invaluable tool in capturing the patient-specific characteristics, thereby providing a more accurate platform for studying tumor biology and testing Dive into a new era of oncology, where your individuality guides our innovation.

Our WES analysis of 5 cholangiocarcinoma (hCCA) samples has shown that the top 30 gene mutations are prominently present across all samples, indicating a high level of mutation.
These findings suggest that conducting experiments with our diverse range of gastric cancer samples is likely to produce results closely mirroring those observed in actual human cases.
Using hCCA Organoid, we statistically analyze the correlation between genetic mutations in proteins and protein-to-protein databases to confirm the associative relationships of genes.

Embrace personalized medicine with our cutting-edge platform: Test your drug’s effectiveness against conventional treatments under optimal conditions and discover tailored therapeutic responses.
Transform the standard with us—where your medication’s potential is as unique as you are.

hCCA Gemcitabine

hCCA Cisplatin

hCCA Paclitaxel

hCCA 5-FU
We have confirmed varying efficacy among patients when treating Cholangiocarcinoma organoids derived from patients with representative chemotherapeutic agents such as gemcitabine, Cisplatin, Paclitaxel and 5-FU.
This underscores the potential for selecting personalized drugs tailored to each patient.
Furthermore, matching these treatments with patients genetic profiles could significantly aid in selecting appropriate chemotherapy agents.
We aim to contribute to the advancement of personalized cancer therapy based on these findings.